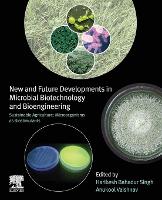

|
|
books
| book details |
New and Future Developments in Microbial Biotechnology and Bioengineering: Sustainable Agriculture: Microorganisms as Biostimulants
Edited by Harikesh Bahadur Singh, Edited by Anukool Vaishnav

|
| on special |
normal price: R 6 878.95
Price: R 6 191.95
|
| book description |
This book provides a comprehensive overview of different agriculturally important microorganisms and their role as plant biostimulants. Arbuscular Mycorrhizal Fungi, Trichoderma, Cyanobacteria, Endophytes, and Plant growth promoting rhizobacteria have the potential to promote plant growth, disease management, nutrient acquisition, stress alleviation, and soil health management. Presenting an all-inclusive collection of information, this book will be important for students, academicians, researchers working in the field of sustainable agriculture, microbial technology, and biochemical engineers. It will also be of use for policymakers in the area of food security and sustainable agriculture.
| product details |

Normally shipped |
Publisher | Elsevier - Health Sciences Division
Published date | 9 Nov 2021
Language |
Format | Paperback / softback
Pages | 390
Dimensions | 235 x 191 x 0mm (L x W x H)
Weight | 450g
ISBN | 978-0-3238-5163-3
Readership Age |
BISAC | technology / engineering / chemical & biochemical
| other options |

Normally shipped |
Readership Age |
Normal Price | R 9 827.95
Price | R 8 844.95
| on special |
|
|
To view the items in your trolley please sign in.
| sign in |
|
|
|
| specials |
|
An epic love story with the pulse of a thriller that asks: what would you risk for a second chance at first love?
|
|
|
|
Mason Coile
Paperback / softback
224 pages
was: R 520.95
now: R 468.95
|
A terrifying locked-room mystery set in a remote outpost on Mars.
|
|
|
|